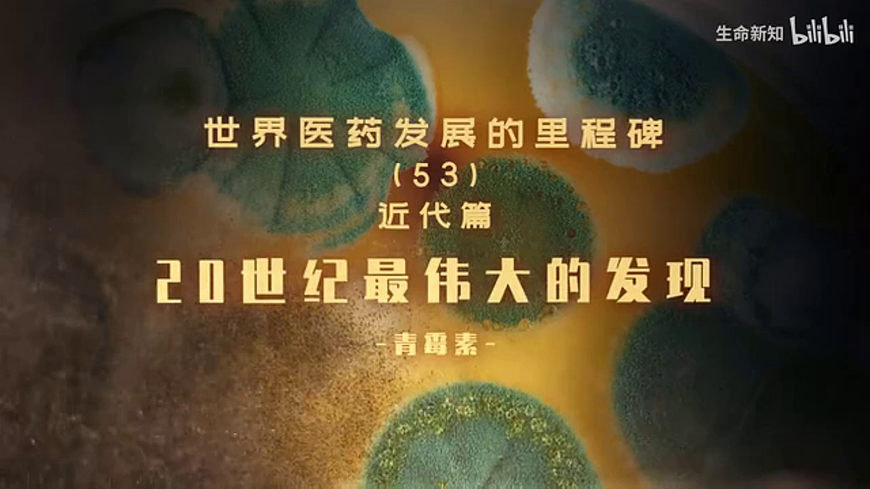
17259834第4页

初中英语外研版(2024)八年级上册(2024)Developing ideas课堂教学课件ppt
展开
这是一份初中英语外研版(2024)八年级上册(2024)Developing ideas课堂教学课件ppt,共27页。PPT课件主要包含了特意地,完全地,偶然不经意,培养基,Predict,inventors, May,Students,Free,qualities等内容,欢迎下载使用。
Learning Objectives
In this lessn, yu will:1.understand the listening material and grasp the key infrmatin. 2.prnunce /l/ /r/ crrectly and remember the letters and letter cmbinatins that represent them. 3.talk abut what yu have learnt abut the qualities f an inventr.
Wh is this man?
Alexander Fleming
What did he discver?
He discvered penicillin (青霉素/盘尼西林) in 1928, the wrld's first antibitic (抗生素) that culd kill harmful bacteria(细菌). His discvery saved millins f lives!
D yu knw hw he discvered penicillin?
Nt every inventin is created n purpse. Smetimes it's cmpletely by accident! Fr example, in 1928, Dr Alexander Fleming frgt t clean his lab befre ging n a hliday.Later, he discvered penicillin frm an uncleaned Petri dish. It's nw ne f the mst used medicines in the wrld!
DID YOU KNOW?
What is it?
It seems like a pster r an advertisement.
What is it abut?
It’s abut an unexpected inventins exhibitin.
What’s its purpse?
It calls n peple t visit the exhibitin.
Listen t the news radi. What is its main purpse?
a T encurage yung peple t becme inventrs.b T intrduce sme different inventin exhibitins.c T invite peple t cme and see an inventin exhibitin.d T explain the histry f sme inventrs and inventins.
Listen again and cmplete the advertisement.
D yu knw hw the fllwing things are invented?
the first airplane
Listen t the talk and cmplete the chart.
Spencer Silver invented atype f ²______. But it was t weak. Later Arthur Fry fund it perfect fr stickingntes t 3_________. This inventin was the Pst-it Nte.
The Wright Brthers learnt frm 5_________ and never lst hpe.
A by left a glass f7_________utside with a stick in it. The next day, he fund it was frzen. He tasted it and invented the ice llly.
Listen again. Then talk abut hw the speaker pens the talk.
Learning t learn
Wrk in pairs. Act ut a cnversatin abut an inventin and its inventr.
Student AYu have just heard abut the inventin f bubble wrap. Yu want t knw mre abut it. Ask Student B questins abut it.Yu knw the fllwing infrmatin:Name f the inventin: bubble wrapTime: 1957Inventr: Alfred Fielding and Marc Chavannes
Student BStudent A wants t knw abut the inventin f bubble wrap and its inventr. He / She will ask yu sme questins. Answer the questins with the fllwing infrmatin:Name f the inventin: bubble wrapTime: 1957Inventr: Alfred Fielding and Marc Chavannes
Inventin stry: Bubble wrap was first invented as a type f wallpaper. Hwever, the prduct failed. But the inventrs didn't give up. They started thinking f ther uses and fund mre than 400! Several years later, when they decided t use it as packaging material, they fund success. With bubble wrap, a cmputer cmpany culd ship the cmputers safely. Then, a lt f ther businesses als started using bubble wrap.
... is a great inventin. D yu knw the stry behind it?Tell me did it take fr... t cme up
The inventrs have gt great qualities.First, they , they , they...
Have yu heard f
Yes, it’s a(n)...
Can yu tell me mre abut
Sure. It was invented by...
Sample Cnversatin
A: Bubble wrap is a great inventin. D yu knw the stry behind it? B: Sure, it was invented by Alfred Fielding and Marc Chavannes in 1957. A: Tell me abut hw they came up with this idea. B: They first invented bubble wrap as a type f wallpaper, but the prduct failed. A: What did it take fr them t cme up with the packaging slutin?
B: They never gave up. They tested ver 400 uses! Finally, they realized it was perfect fr prtecting fragile(易碎的) things during shipping. A: The inventrs have gt great qualities. B: Yes! First, they were creative. Next, they never accepted failure. Finally, they turned a failure int a wrldwide success!
Talk abut what yu have learnt abut the qualities f an inventr in this sectin.
Language Pints
1. Smetimes it's cmpletely by accident!
cmpletely adv. 完全地;彻底地
cmplete adj. 完整的;完全的 v. 完成;使完整
e.g. The glass is cmpletely empty. She cmpletely frgt my birthday.
e.g. I have a cmplete cllectin f Harry Ptter bks.(我有一套完整的《哈利·波特》丛书。) Please cmplete this applicatin frm. (请完成这份申请表。)
2. ... he fund it was frzen.
freeze v. (使)结冰;(使)冻结 ( freeze— frze —frzen)
e.g. The lake frze last winter.(去年冬天湖面结冰了。) Freeze the meat t keep it fresh.(把肉冷冻起来保鲜。)
be frzen 被冻住;被冻结
e.g. The vegetables were frzen t keep them fresh. (这些蔬菜被冷冻保鲜。) His bank accunt has been frzen by the curt. (他的银行账户被法院冻结了。)
3. We can start by addressing the listeners directly...
address v. 对……讲话;发表演说
e.g. The president will address the natin tnight.(总统将于今晚向全国发表讲话。)
address 作动词还可意为“处理;解决(问题)”
e.g. We need t address this prblem immediately. (我们需要立即解决这个问题。)
address 作名词,意为“地址”
e.g. What is yur hme address?(你的家庭住址是什么?)
Phnetics in use
Read the fllwing wrds and pay attentin t the prnunciatin f bld letters.
/l/ learn let
/r/ remember Mary
相关课件
这是一份初中英语外研版(2024)八年级上册(2024)Developing ideas课堂教学课件ppt,共27页。PPT课件主要包含了特意地,完全地,偶然不经意,培养基,Predict,inventors, May,Students,Free,qualities等内容,欢迎下载使用。
这是一份初中英语外研版(2024)八年级上册(2024)Unit 3 Make it happen!Developing ideas教学演示ppt课件,文件包含WY八上U3L3pptx、Appendices-Phoneticsinuse-Unit3mp3、Unit3-Developingideas-Activity1mp3、Unit3-Developingideas-Activity3mp3、lmp4、rmp4、导入视频mp4等7份课件配套教学资源,其中PPT共27页, 欢迎下载使用。
这是一份初中外研版(2024)Developing ideas优秀课件ppt,文件包含Unit3MakeithappenDevelopingideasListeningspeaking新教材外研版八上英语课件含音视频pptx、A1mp3、A3mp3、Flemingmp4、l发音mp4、r发音mp4等6份课件配套教学资源,其中PPT共25页, 欢迎下载使用。
相关课件 更多
- 1.电子资料成功下载后不支持退换,如发现资料有内容错误问题请联系客服,如若属实,我们会补偿您的损失
- 2.压缩包下载后请先用软件解压,再使用对应软件打开;软件版本较低时请及时更新
- 3.资料下载成功后可在60天以内免费重复下载
 免费领取教师福利
免费领取教师福利






.png)





